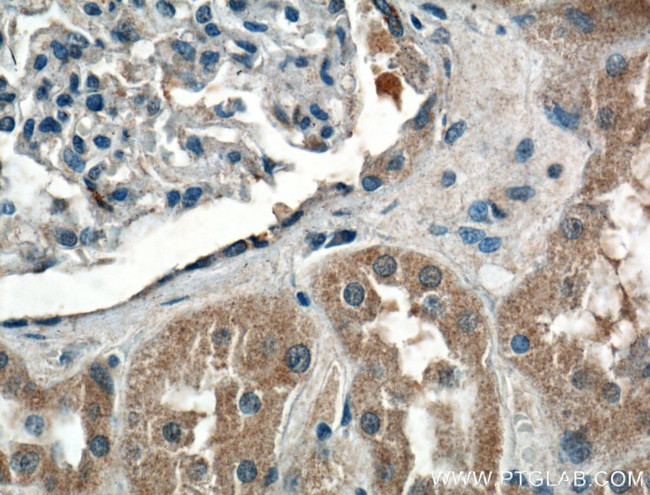
CCBE1 Antibody in Immunohistochemistry (Paraffin) (IHC (P))

Search
Proteintech
CCBE1 Polyclonal Antibody
{{$productOrderCtrl.translations['antibody.pdp.commerceCard.promotion.promotions']}}
{{$productOrderCtrl.translations['antibody.pdp.commerceCard.promotion.viewpromo']}}
{{$productOrderCtrl.translations['antibody.pdp.commerceCard.promotion.promocode']}}: {{promo.promoCode}} {{promo.promoTitle}} {{promo.promoDescription}}. {{$productOrderCtrl.translations['antibody.pdp.commerceCard.promotion.learnmore']}}
产品信息
24449-1-AP
种属反应
宿主/亚型
分类
类型
抗原
偶联物
形式
浓度
规格
纯化类型
保存液
内含物
保存条件
运输条件
产品详细信息
Immunogen sequence: MVKAGTCCA TCKEFYQMKQ TVLQLKQKIA LLPNNAADLG KYITGDKVLA SNTYLPGPPG LPGGQGPPGS PGPKGSPGFP GMPGPPGQPG PRGSMGPMGP SPDLSHIKQG RRGPVGPPGA PGRDGSKGER GAPGPRGSPG PPGSFDFLLL MLADIRNDIT ELQEKVFGHR THSSAEEFPL PQEFPSYPEA MDLGSGDDHP RRTETRDLRA PRDFYP (192-406 aa encoded by BC046645)
靶标信息
The gene encoding CCBE1 (Collagen and calcium-binding EGF domain-containing protein 1) is located on chromosome 18 in a region that is frequently found to be deleted in breast and prostate cancers. CCBE1 is a 406 amino acid secreted protein that contains two collagen-like domains and one calcium-binding epidermal growth factor (EGF-like) domain. In general, EGF-like domains include six cysteine residues that are usually involved in disulfide bonds. Calcium-binding EGF-like domains are subject to amino acid substitutions that disrupt their structure or calcium affinity, therefore altering protein function. Downregulation of the gene encoding CCBE1 is observed with high frequency in breast cancer, suggesting that loss of CCBE1 results in changes in cell adhesion and mobility due to its characterization as an extracellular protein. There are three named isoforms of CCBE1 which are produced as a result of alternative splicing events.
仅用于科研。不用于诊断过程。未经明确授权不得转售。
篇参考文献 (0)
生物信息学
蛋白别名: Collagen and calcium-binding EGF domain-containing protein 1; FLJ30681; Full of fluid protein homolog; MGC50861
基因别名: CCBE1; HKLLS1; KIAA1983; UNQ1921/PRO4395
UniProt ID: (Human) Q6UXH8
Entrez Gene ID: (Human) 147372